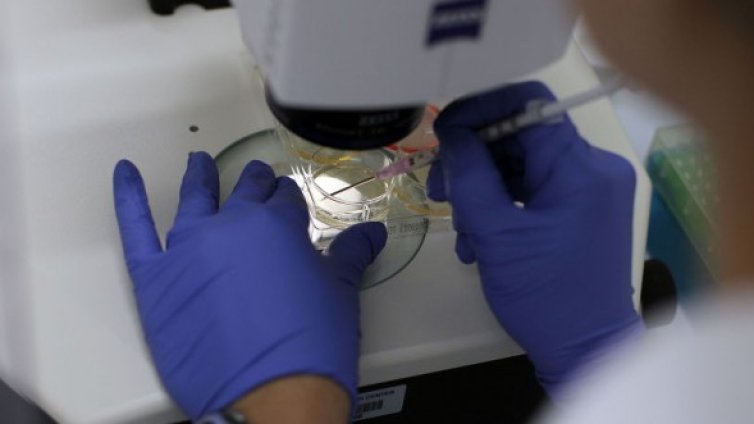
Учени напредват в битката със СПИН-а

Новини
-
Полша ще купи три подводници за $4,8 милиарда от Швеция
-
Летни жеги: До 43° ще е през юли, ще вали малко
-
Удостояват Йотова с почетното звание “Доктор хонорис кауза“ на БАН
-
Как може Володимир Зеленски да говори за край на конфликта за 40 дни?
-
Кампанията "Лято без дрога": Няма наркотик, който да реши проблем
-
Най-много сме пътували към Турция и Гърция през май
-
Издирват “Батман от Мексико”, лепял с тиксо крадци на уличните лапми
-
Морален казус: Таксиметров шофьор засне младо момиче в София, пусна я в интернет
-
Роднини на 11-те жертви станали свидетели на катастрофата с малък самолет край Нанси
-
Протест в София против кабинета "Радев": "Оставка“, "Тук не е Москва" СНИМКИ
-
Олег Невзоров: Продължаваме да изпълняваме всички поети наши задължения, работим по проектите ни
-
Месечна прогноза: Очаква ни парещ юли, температурите стигат 40°С
-
Първият "бременен мъж“ в света Томас Бийти разказва историята си за първи път
-
Авиационна трагедия с последствия и днес: Денят, в който 4 атомни бомби паднаха над Испания
-
Протест в София против кабинета "Радев": "Оставка“, "Тук не е Москва" СНИМКИ
-
Морален казус: Таксиметров шофьор засне младо момиче в София, пусна я в интернет
-
Борисов обяви: ГЕРБ гради алтернативно правителство за деня, в който ще управляваме
-
Първият "бременен мъж“ в света Томас Бийти разказва историята си за първи път
-
Николай Василев към властта: Некадърност, страх и мързел! Изхвърлете този бюджет
-
Путин призна: Преминаваме през труден период, обеща да се справи с предизвикателствата
-
Редом до Левски: Магнити с лика на Тодор Живков се продават за 1 евро във Враца

Новата емисия облигации на „Елана Агрокредит“ ще се търгува на БФБ от 2 юли
Новата емисия облигации на „Елана Агрокредит“ ще се търгува на БФБ от 2 юли  Няма пълно съгласие за бюджета на ДОО, работодатели и синдикати поставиха условия за подкрепа
Няма пълно съгласие за бюджета на ДОО, работодатели и синдикати поставиха условия за подкрепа  Рекордни жеги изгарят Европа - Част 2
Рекордни жеги изгарят Европа - Част 2  Какво означава ефектът Ел Ниньо за пазарите?
Какво означава ефектът Ел Ниньо за пазарите?  Индексите на Wall Street се повишават благодарение на акциите в технологичния сектор*
Индексите на Wall Street се повишават благодарение на акциите в технологичния сектор*  „Български пощи“ въвежда такса за обмяна на левове в евро от 1 юли
„Български пощи“ въвежда такса за обмяна на левове в евро от 1 юли 
 Върховният съд на САЩ отхвърли жалбата на Тръмп по дело за сексуално насилие срещу писателка
Върховният съд на САЩ отхвърли жалбата на Тръмп по дело за сексуално насилие срещу писателка  Брутална катастрофа между тир и кола блокира движението по АМ "Тракия"
Брутална катастрофа между тир и кола блокира движението по АМ "Тракия"  НСО съобщи колко струва държавната охрана на Пеевски
НСО съобщи колко струва държавната охрана на Пеевски  Владимир Кличко пристигна в София и започна серия срещи на високо равнище (+СНИМКИ)
Владимир Кличко пристигна в София и започна серия срещи на високо равнище (+СНИМКИ)  Прокуратурата проверява таксиметров шофьор, снимал пияна жена, която заспала в колата
Прокуратурата проверява таксиметров шофьор, снимал пияна жена, която заспала в колата  Оставиха в ареста ръководителя на ВиК-Несебър и Поморие Свилен Станчев
Оставиха в ареста ръководителя на ВиК-Несебър и Поморие Свилен Станчев 
 Рано е Виртц и Мусиала да бъдат сравнявани с Меси, Мбапе и Холанд
Рано е Виртц и Мусиала да бъдат сравнявани с Меси, Мбапе и Холанд  Левски представи официално новия екип за сезон 2026/2027 + ВИДЕО
Левски представи официално новия екип за сезон 2026/2027 + ВИДЕО  Дейвид Бекъм блесна на „Уимбълдън“ – гледа Яник Синер от Кралската ложа
Дейвид Бекъм блесна на „Уимбълдън“ – гледа Яник Синер от Кралската ложа  Левски готви двоен трансферен бум – представя Сержиньо и Мехди Мубарик днес
Левски готви двоен трансферен бум – представя Сержиньо и Мехди Мубарик днес  Бразилски легенди на бенефиса на Салпаров
Бразилски легенди на бенефиса на Салпаров  Ман Сити официално назначи Енцо Мареска за нов мениджър
Ман Сити официално назначи Енцо Мареска за нов мениджър 
 Пълнолуние в Козирог на 30 юни: Какво да очаква всяка зодия
Пълнолуние в Козирог на 30 юни: Какво да очаква всяка зодия  Дневен хороскоп за 30 юни, вторник
Дневен хороскоп за 30 юни, вторник  20 закона на Мърфи за живота
20 закона на Мърфи за живота  Гръцка салата с паста – рецепта
Гръцка салата с паста – рецепта  ИГРА: Участвайте и можете да спечелите награди от филма „Миньони & чудовища“
ИГРА: Участвайте и можете да спечелите награди от филма „Миньони & чудовища“  Седмична нумерологична прогноза за 29 юни – 5 юли
Седмична нумерологична прогноза за 29 юни – 5 юли 
 продава, Двустаен апартамент, 60 m2 София, Връбница 1, 146000 EUR
продава, Двустаен апартамент, 60 m2 София, Връбница 1, 146000 EUR  продава, Двустаен апартамент, 79 m2 София, Оборище, 223000 EUR
продава, Двустаен апартамент, 79 m2 София, Оборище, 223000 EUR  продава, Двустаен апартамент, 67 m2 София, Малинова Долина, 160872 EUR
продава, Двустаен апартамент, 67 m2 София, Малинова Долина, 160872 EUR  продава, Двустаен апартамент, 59 m2 София, Център, 173652 EUR
продава, Двустаен апартамент, 59 m2 София, Център, 173652 EUR  продава, Двустаен апартамент, 52 m2 София, Манастирски Ливади, 129000 EUR
продава, Двустаен апартамент, 52 m2 София, Манастирски Ливади, 129000 EUR  продава, Двустаен апартамент, 61 m2 Бургас, Черно море, 95002 EUR
продава, Двустаен апартамент, 61 m2 Бургас, Черно море, 95002 EUR 
 Какво време ни очаква във вторник?
Какво време ни очаква във вторник?  Единственият арестуван по аферата „Баба Алино“ излезе от ареста срещу "подписка"
Единственият арестуван по аферата „Баба Алино“ излезе от ареста срещу "подписка"  37 пияни или дрогирани водачи спипа КАТ за ден
37 пияни или дрогирани водачи спипа КАТ за ден  Излетя и последният US самолет от Летище София
Излетя и последният US самолет от Летище София  Варна подобри 72-годишен температурен рекорд днес
Варна подобри 72-годишен температурен рекорд днес  Стрелба в Германия: Петима са убити (ВИДЕО)
Стрелба в Германия: Петима са убити (ВИДЕО) 
 „Изгубеният град“: Може ли подводна планина да разкрие тайната за произхода на живота?
„Изгубеният град“: Може ли подводна планина да разкрие тайната за произхода на живота?  Учени предлагат: Гигантски огнени торнада да почистват нефтени разливи в океана
Учени предлагат: Гигантски огнени торнада да почистват нефтени разливи в океана  НАСА разработва технология за презареждане в орбита за мисии в далечния космос
НАСА разработва технология за презареждане в орбита за мисии в далечния космос  Китайската космическа станция прелетя над Луната: Илюзия или реалност? (снимки)
Китайската космическа станция прелетя над Луната: Илюзия или реалност? (снимки)  AI подкопава доверието: Невронните мрежи се научиха да заблуждават експертите
AI подкопава доверието: Невронните мрежи се научиха да заблуждават експертите  Китай ще изстреля за първи път ракетата „Чанджън-10B“ през юли
Китай ще изстреля за първи път ракетата „Чанджън-10B“ през юли